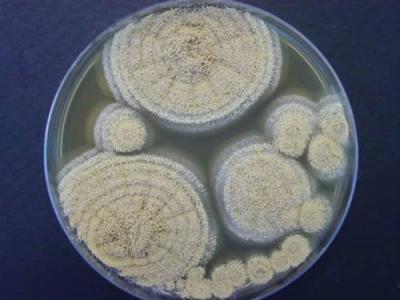

नवा धोका! देशात पहिल्यांदाच एस्परजिलियस लेंटुलसमुळे दोन मृत्यू; नव्या फंगसपुढे औषधही फेल
By ऑनलाइन लोकमत | Published: November 23, 2021 11:48 AM2021-11-23T11:48:50+5:302021-11-23T11:51:33+5:30
अदृश्य शत्रूमुळे डॉक्टर्स चकीत; एस्परजिलियस लेंटुलसमुळे दिल्ली एम्समध्ये दोघांचा मृत्यू

देशाला असलेला कोरोनाचा धोका कायम आहे. तिसरी लाट टाळण्यासाठी लसीकरण वेगानं सुरू आहे. मात्र आता कोरोना संकटात आणखी एका संकटाची भर पडली आहे. त्यामुळे डॉक्टरांची चिंता वाढली आहे.

दिल्लीत नव्या फंगसमुळे होणाऱ्या मृत्यूंमुळे चिंतेत भर पडली आहे. एम्समध्ये दोन रुग्णांना एस्परजिलियस लेंटुलस नावाच्या फंगसची लागण झाली. या प्रकारच्या फंगसवर कोणत्याही औषधाचा परिणाम होत नाही.

क्रॉनिक ऑब्स्ट्रक्टिव पल्मोनरी डिजीजचा सामना करत असलेल्या दोन्ही रुग्णांचा उपचारादरम्यान मृत्यू झाला. एस्परजिलियस लेंटुलस फुफ्फुसावर परिणाम करतं. २००५ मध्ये वैद्यकीय जगताला या फंगसची औषध पटली. तेव्हापासून आतापर्यंत अनेक देशांमध्ये एस्परजिलियस लेंटुलसचे रुग्ण आढळून आले आहेत.

भारतात पहिल्यांदाच एस्परजिलियस लेंटुलसचे रुग्ण आढळून आले आहेत. इंडियन जर्नल ऑफ मेडिकल मायक्रोबायोलॉजीमध्ये (IJMM)प्रकाशित झालेल्या अहवालानुसार एस्परजिलियस लेंटुलसमुळे मृत्यूमुखी पडलेल्या एका रुग्णाचं वय ५० ते ६० वर्षांदरम्यान, तर दुसऱ्या रुग्णाचं वय ४५ वर्षांपेक्षा कमी होतं.

पहिल्या रुग्णावर एका खासगी रुग्णालयात उपचार सुरू होते. मात्र प्रकृतीत सुधारणा न झाल्यानं त्यांना एम्समध्ये हलवण्यात आलं. त्यांना Amphotericin B आणि ओरल Voriconazole इंजेक्शन्स देण्यात आली. मात्र महिन्याभरानंतरही त्यांची प्रकृती सुधारली नाही आणि त्यांचा मृत्यू झाला.

दुसऱ्या रुग्णाला ताप, खोकला आणि श्वास घेण्यास त्रास सुरू होता. त्यासाठी त्याला एम्समध्ये दाखल करण्यात आलं. त्यालाही Amphotericin B देण्यात आलं. मात्र आठवड्याभरातच शरीरातील अनेक अवयव निकामी झाल्यानं त्याचा मृत्यू झाला.

एका दशकापूर्वी २०० ते ३०० फंगसमुळेच माणूस आजारी पडायचा. मात्र आता या प्रजातींची संख्या ७०० च्या पुढे गेली असल्याचं डॉ. अरुणलोक चक्रवर्तींनी सांगितलं. ते जागतिक आरोग्य संघटनेच्या फंगस केंद्राचं नेतृत्त्व करतात. ७०० पैकी अनेक प्रजातींवर औषधांचा परिणाम होत नसल्याचं त्यांनी सांगितलं.

बुरशीमुळे होणाऱ्या आजारांना फंगल इन्फेक्शन म्हटलं जातं. बुरशी पर्यावरणात आढळून येते. बुरशीमुळे होणारे बरेचसे संसर्ग लगेच बरे होतात. मात्र काही संसर्ग अतिशय घातक ठरतात. त्यामध्ये कँडिडा किंवा एस्परजिलियस फंगसमुळे होणाऱ्या संसर्गाचा समावेश होतो.
फंगसमुळे होणाऱ्या संसर्गामुळे जगभरात दरवर्षी जवळपास १५ लाख लोकांचा मृत्यू होतो. रोगप्रतिकारशक्ती कमी असलेल्या, मधुमेह आणि किडनीच्या आजारांचा सामना करणाऱ्यांना फंगसचा धोका अधिक असतो.

अँटीबायोटिक्सच्या अतिवापरामुळेही फंगसचा धोका वाढतो. अँटीबायोटिक्सच्या अतिसेवनामुळे शरीरातील दोन्ही प्रकारचे (चांगले आणि वाईट) बॅक्टेरिया मरतात. त्यामुळे बुरशीची वाढ होण्यास अनुकूल स्थिती निर्माण होते.

















